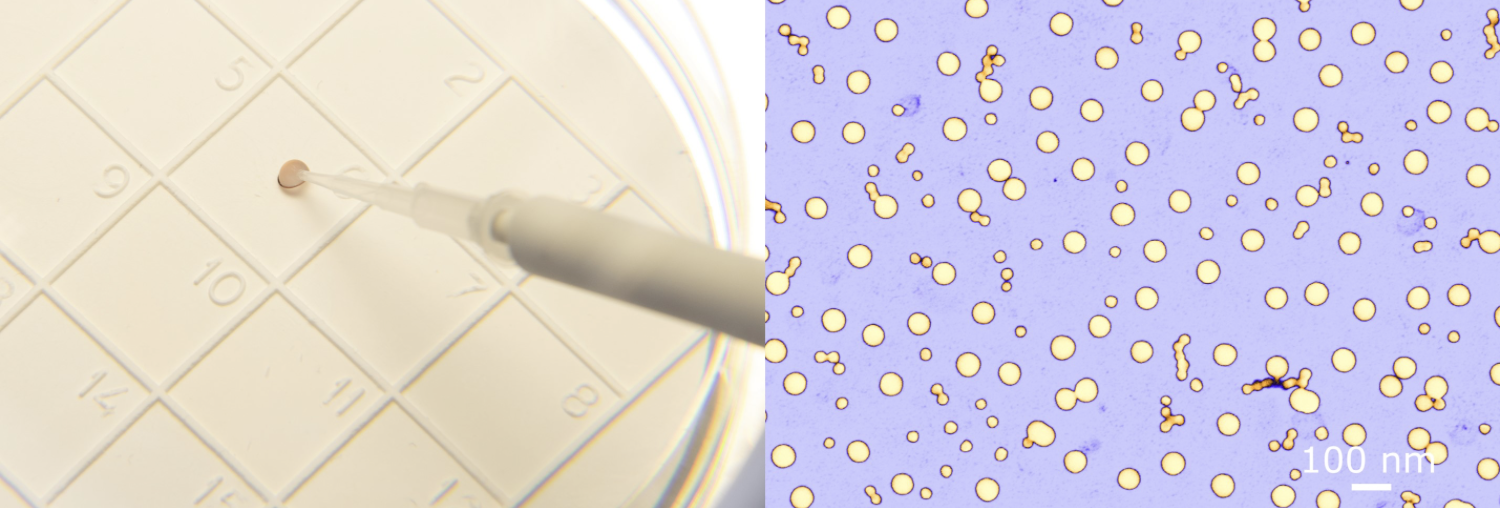
BAM event image

Past Events
 19 September 2024, 9:00-13:00
19 September 2024, 9:00-13:00
This workshop will focus on the Strategic Research & Innovation Agenda (SRIA) for Innovative Advanced Materials set by the IAM4EU partnership. During the event, we will present the content SRIA, engage in discussions, and collaboratively refine this document based on the outcomes of these discussions. Your expertise and insights will be invaluable in shaping the future of advanced materials research in Europe!

2D materials have triggered enormous interest over the past 15 years, thanks to their interesting electronic and optical properties, which have propelled them as viable candidates for replacing/complementing the good-old Silicon in future semiconductor technology nodes. Nevertheless, several tough challenges need to be addressed to take the opportunities ahead.
In this workshop, we will give an account of a few relevant R&D areas, outlining key attention points in material growth, integration, and reliability, and we will sample applications domain opportunities, underlining the unique advantages of the 2D materials, which recommend them as prime contenders for continuing the physical/functional scaling, as well as for expanding into the applications space, for the years/decades to come.

ARMS, GRAPHERGIA, SOLiD and SUPERIOT will hold the joint workshop "Synergizing Sustainability: Integrating Advanced Energy Storage with Harvesting for Wearable Electronics" on June 30 from 14:00 to 17:00. This workshop will delve into the forefront of energy-autonomous self-powered wearable electronic devices, focusing on the dynamic interaction between energy harvesting systems and transformative energy storage solutions, specifically batteries and supercapacitors.

If you are attending Graphene 2024, don't miss Graphene Flagship project GIANCE's workshop on June 26. Discover insights on sustainable graphene, printed technologies, graphene-based membranes, and more.
Also, Kari Hjelt from Chalmers Industriteknik will be talking about the 10 years of Graphene Flagship and the way ahead, offering unique insights you won’t want to miss!

Materials Week 2024 aims to bring together – for the first time – the numerous small and large Research and Innovation (R&I) communities that are driving advances in materials innovation manifested across diverse value chains and industrial markets. The Graphene Flagship is responsible for the session on Sustainability & Circularity driven by Advanced Materials.
You can also find us in the following training courses: "How to expand the use of your test method? – Validation is key towards standardisation" and "Standardisation needs for regulatory testing of graphene and related 2D materials".

This free, lunch-to-lunch event will celebrate the 2D Experimental Pilot Line (2D-EPL) results and its progress towards creating an ecosystem for 2D materials integration in semiconductors for electronics, photonics, sensors and biomedical devices. The symposium will focus on photonics and biomedical applications and the benefits and challenges of industrial uptake for these technologies.

Join a free webinar to learn about the possibility to have custom graphene devices fabricated during the upcoming multiproject wafer run at 2D-EPL!

Advanced materials, such as nanomaterials, 2D materials, or thin films, play a crucial role in driving economic development and addressing major challenges in the coming years. These challenges include mitigating the impact of climate change, advancing lightweight engineering, enhancing catalysis, and improving medical applications.
To comprehend the performance of these materials and ensure their acceptance across various sectors as safe and sustainable for both humans and the environment, the availability of reference procedures, materials, and data is essential. One versatile tool for establishing such references and evaluating the proficiency of individual laboratories and their competencies is through (international) interlaboratory comparisons (ILC). Notably, initiatives like the Versailles Project on Advanced Materials and Standards (VAMAS) provide a platform for conducting ILCs.
This webinar will showcase various examples of interlaboratory comparisons, illustrating their impact on the development of reference products.

This workshop, hosted by the Graphene Flagship's 2D-EPL and its partner AMO, will examine electronics based on transition metal dichalcogenides (TMDCs). This free hybrid event will take place in Aachen, Germany as part of the two-day event on 2D Materials for Future Electronics. Attendees are welcome to join in-person for the full two-day event, or online for the 2-hour digital 2D-EPL workshop.

A major challenge in using 2D-materials is linked to the impact of the environment on its properties. These effects are mitigated by careful material and process selection. The transition from lab–to–fab is enabled by setting up dedicated tools and processes. Gaining insights on the source of process variations and their impact on the variability of device parameters is key to making the right choices in the set-up of pilot-line processes.

In this workshop, organised as part of the Graphene Week 2023 programme, attendees had the chance to learn about the ongoing research activities and real-world technology transfer applications in the United Arab Emirates, including spin-offs from the Graphene Flagship.
The Research & Innovation Center for Graphene and 2D Materials, at Khalifa University, is very focused on the commercialization of research and addresses challenges from the region with innovations in construction, health care, aerospace, energy and water purification.
Apart from presentations, this session provided opportunities to discuss topics of common interest, explore possible new collaborations, and a Q&A session.

This year's event included 1-to-1 career coaching sessions and talks about creating a healthy work culture.

Graphene Week 2023 inspired a fusion of graphene research and technology with industrial innovation – it is where science meets business! The Graphene Innovation Forum is a good spot to learn about the latest graphene innovations, spin-off company successes, and the future of the graphene industry.

Graphene Week 2023 - FROM WONDER TO ACTION - marks not only the Graphene Flagship’s 10-year anniversary celebration, but also the 400th birthday of Graphene Week 2023’s host city, Gothenburg – and celebrations of these two milestones coincided in Gothenburg, 4-8 September 2023.
Join us this year for Graphene Week 2024 in Prague, 14-18 October 2024

Every second year, Euronanoforum brings industry, academia, policy makers and other stakeholders together to discuss developments on nanotechnologies in an open forum. In 2023, the EuroNanoForum will be held in Sweden, 11-13 June. The Graphene Flagship will exhibit and contribute to the event's scientific programme.